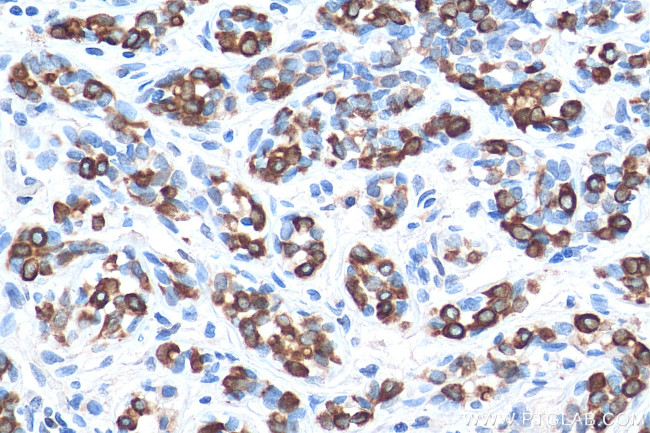
TNF alpha Antibody in Immunohistochemistry (Paraffin) (IHC (P))

Search
Proteintech
TNF alpha Monoclonal Antibody (7B8A11)
{{$productOrderCtrl.translations['antibody.pdp.commerceCard.promotion.promotions']}}
{{$productOrderCtrl.translations['antibody.pdp.commerceCard.promotion.viewpromo']}}
{{$productOrderCtrl.translations['antibody.pdp.commerceCard.promotion.promocode']}}: {{promo.promoCode}} {{promo.promoTitle}} {{promo.promoDescription}}. {{$productOrderCtrl.translations['antibody.pdp.commerceCard.promotion.learnmore']}}
产品信息
60291-1-IG
种属反应
已发表种属
宿主/亚型
分类
类型
克隆号
抗原
偶联物
形式
浓度
规格
纯化类型
保存液
内含物
保存条件
运输条件
产品详细信息
Immunogen sequence: MSTESMIRD VELAEEALPK KTGGPQGSRR CLFLSLFSFL IVAGATTLFC LLHFGVIGPQ REEFPRDLSL ISPLAQAVRS SSRTPSDKPV AHVVANPQAE GQLQWLNRRA NALLANGVEL RDNQLVVPSE GLYLIYSQVL FKGQGCPSTH VLLTHTISRI AVSYQTKVNL LSAIKSPCQR ETPEGAEAKP WYEPIYLGGV FQLEKGDRLS AEINRPDYLD FAESGQVYFG IIAL (1-233 aa encoded by BC028148)
靶标信息
TNF alpha is a multifunctional proinflammatory cytokine that belongs to the tumor necrosis factor (TNF) superfamily. This cytokine is mainly secreted by macrophage and bind to its receptors, TNFRSF1A/TNFR1 and TNFRSF1B/TNFBR. TNF alpha is involved in the regulation of immune cells, cell proliferation, differentiation, apoptosis, lipid metabolism, and coagulation. TNF alpha exists as a multimer of two, three, or five noncovalently linked units, but shows a single 17 kDa band following SDS-PAGE under non-reducing conditions. Knockout studies in mice also suggested the neuroprotective function of TNF alpha, and has been observed to causes tumor necrosis when injected into tumor-bearing mice. Other functions of TNF-alpha include its role in the immune response to bacterial, viral, parasitic and certain fungal infections, as well as its role in the necrosis of specific tumors. TNF alpha causes cytolysis or cytostasis of certain transformed cells, being synergistic with interferon-gamma in its cytotoxicity. This cytokine has been implicated in a variety of diseases, including autoimmune diseases, insulin resistance, and cancer.
仅用于科研。不用于诊断过程。未经明确授权不得转售。
生物信息学
蛋白别名: APC1 protein; Cachectin; cell apoptosis-related protein; DADB-70P7.1; TNF alpha; TNF superfamily; TNF superfamily member 2; TNF α; TNF, macrophage-derived; TNF, monocyte-derived; TNF-a; TNF-alpha; TNFα; Tumor necrosis factor; tumor necrosis factor (TNF superfamily, member 2); tumor necrosis factor alpha; tumor necrosis factor ligand 1F; Tumor necrosis factor ligand superfamily member 2; tumor necrosis factor-alpha; tumor necrotic factor alpha; unnamed protein product
基因别名: DIF; IMD127; RATTNF; TNF; TNF-a; TNF-alpha; TNFA; TNFalpha; Tnfsf1a; TNFSF2; TNLG1F
UniProt ID: (Human) P01375, (Rat) P16599, (Mouse) P06804
Entrez Gene ID: (Human) 7124, (Rat) 24835, (Mouse) 21926